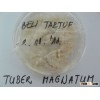

- MICELIUM FOR TUBER MAGNATUM/TUBER AESTIVUM
- 2016-07-18 18:36
- Product Type:TrufflesColor:white/yellow and ligh brownShape:miceliumSource:WildProcessing Type:miceliumPart:miceliumPlac

- white truffles
- 2016-07-18 17:40
- Product Type:TrufflesStyle:FreshColor:WhiteSource:WildPart:WholePlace of Origin:SerbiaSerbia:SerbiaBrand Name:fresh whit